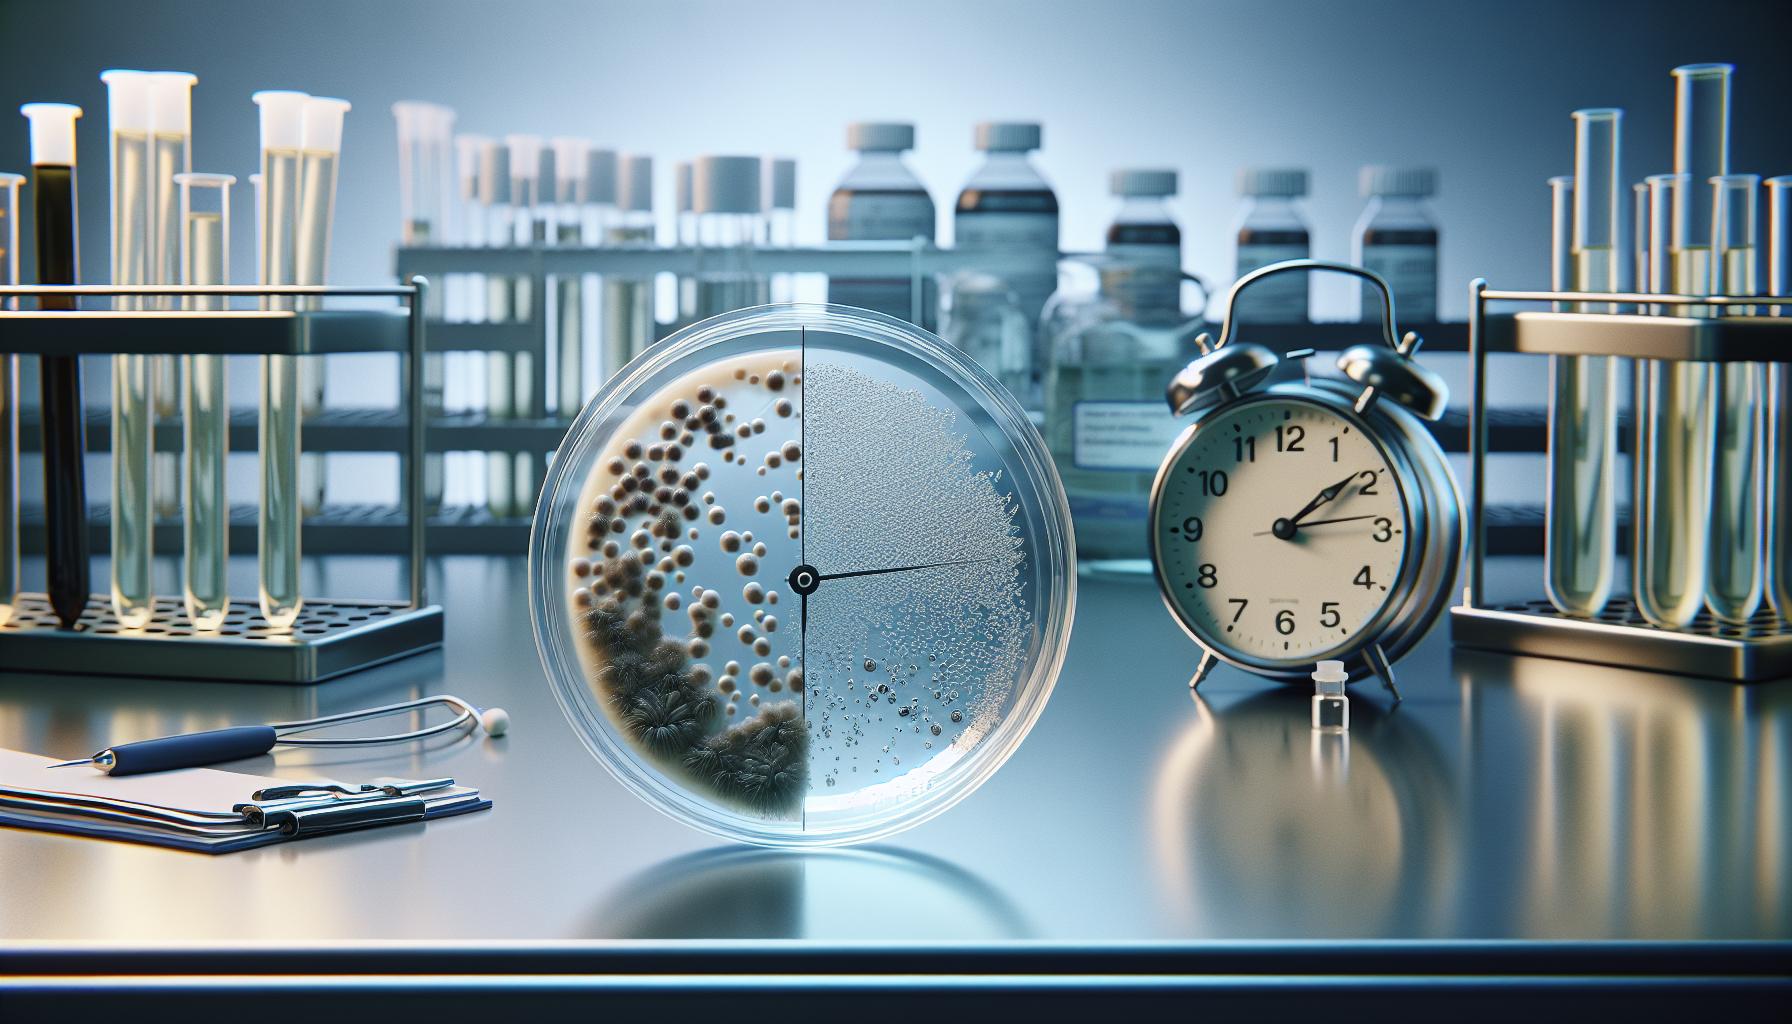
Timeframe for Ivermectin's Antimicrobial Effects

Ivermectin is a widely used antiparasitic medication that has transformed the treatment of various infections, including scabies and strongyloidiasis. One of the most pressing questions surrounding its use is: how long does it actually take for ivermectin to eliminate these parasites from the body? Understanding this timeline is crucial for both patients and healthcare providers, as it directly impacts treatment efficacy and recovery expectations. Many people grapple with the anxiety of untreatable infections and the hope that ivermectin can provide relief. By delving into the pharmacodynamics of ivermectin, we can uncover the factors that influence its effectiveness, including dosage, timing, and individual patient characteristics. Join us as we explore the science behind ivermectin’s action, the relevance of timing in treatment success, and the broader implications for public health.
How Ivermectin Works in the Body
The mechanism by which ivermectin operates within the body is both fascinating and clinically significant. Ivermectin, a derivative of avermectin, primarily targets parasites by binding to specific ion channels and neurotransmitter receptors in their nervous system. This action disrupts their normal physiological functions, leading to paralysis and eventual death. The drug has a high affinity for glutamate-gated chloride channels, predominantly found in invertebrates. When ivermectin binds to these channels, it causes an influx of chloride ions, resulting in hyperpolarization of the nerve or muscle cells, thus effectively immobilizing the parasites.
In addition to its effects on chloride channels, ivermectin also interacts with the gamma-aminobutyric acid (GABA) receptors in parasites, enhancing their inhibitory effects. This dual action underscores its efficacy against a variety of parasitic infections, including those caused by roundworms, mites, and ectoparasites. Importantly, humans and mammals lack these specific channels, which contributes to the drug’s safety profile when used at therapeutic doses.
Understanding the pharmacokinetics of ivermectin is crucial to its success as a treatment. After administration, ivermectin is absorbed into the bloodstream, where it can be detected at therapeutic levels. Factors such as the method of administration, the presence of food, and individual metabolic differences can influence how quickly and effectively ivermectin acts in the body. For instance, when given orally, it reaches peak plasma concentrations within a few hours, but the rate of absorption and elimination can vary significantly among different species and individuals, necessitating careful consideration in treatment protocol design.
The timeframe for ivermectin’s antimicrobial effects typically begins within hours of administration. However, complete parasitic death may take several days, giving the drug time to exert its effects and allowing the host’s immune system to eliminate the dead parasites. Monitoring is essential during this period to ensure the treatment’s success and address any potential side effects. Knowing how ivermectin operates at a biological level provides a foundation for understanding its role in managing parasitic infections, making it a critical tool in both veterinary and human medicine.
Understanding the Pharmacokinetics of Ivermectin
Understanding how ivermectin behaves in the body is crucial for optimizing its use against parasitic infections. When administered, ivermectin is rapidly absorbed into the bloodstream, where it begins to exert its effects. The pharmacokinetics of this compound-including its absorption, distribution, metabolism, and excretion-are key aspects that influence its therapeutic effectiveness and duration of action.
Ivermectin reaches peak plasma concentrations relatively quickly, typically within 2 to 4 hours after oral administration. However, the exact timing can vary based on several factors, such as the formulation of ivermectin used (oral vs. injectable) and whether it was taken with food. For instance, food can enhance its absorption significantly, affecting its bioavailability and consequently speeding up its onset of action. Understanding that these factors can change the dynamics of treatment helps healthcare providers and patients to plan administration effectively for optimal results.
Interestingly, the elimination half-life of ivermectin varies depending on the route of administration. Intravenously, the half-life is approximately 3.8 times longer than when taken orally, allowing for prolonged effects in certain clinical situations. This characteristic can affect how often doses need to be administered, underscoring the importance of tailoring treatment protocols to individual circumstances. Additionally, variations among species-such as between humans, dogs, and livestock-highlight the necessity for species-specific dosing guidelines to ensure therapeutic efficacy while minimizing risks of toxicity.
The effectiveness of ivermectin is also influenced by individual metabolic factors, such as age, weight, and overall health status. These variations necessitate careful monitoring to assess both the pharmacokinetic profile and the clinical response, ensuring that appropriate adjustments can be made to enhance therapeutic outcomes. By grasping the pharmacokinetic intricacies of ivermectin, practitioners can better leverage its properties to combat parasitic infections efficiently and safely.
Timeframe for Ivermectin’s Antimicrobial Effects
The journey of ivermectin through the body is nothing short of remarkable, and its rapid action against parasites can be striking. Typically, after oral administration, ivermectin reaches its peak plasma concentration within 2 to 4 hours, launching a series of physiological effects aimed at combating infections. However, this swift response can be influenced by several factors, including the formulation of the drug and whether it is taken with food. For instance, consuming ivermectin with a fatty meal can enhance its absorption, potentially hastening the onset of its therapeutic effects.
While ivermectin starts to exert its antimicrobial activity within hours, the complete process of eliminating parasites varies. In many cases, significant parasite reduction can be noted within a few days following administration. Clinical studies often report that the full effects, particularly in the context of resolving symptoms and eliminating detectable parasites, may take several days to weeks. The persistence of ivermectin’s action in the body, with a half-life that can extend considerably depending on administration routes (such as being nearly four times longer when given intravenously), also plays a crucial role in determining how swiftly and effectively the body can combat the infection.
Several factors contribute to the variability in response times among individuals. Age, weight, overall health, and specific metabolic factors can influence how quickly patients respond to ivermectin treatment. For instance, younger patients or those with robust metabolic rates may experience faster antimicrobial effects than older individuals or those with slower metabolism. This heterogeneity calls for individualized treatment plans, where healthcare providers may need to monitor patient responses closely and adjust dosages accordingly to optimize efficacy.
Overall, understanding the is essential for both healthcare providers and patients. It enables better expectations management regarding treatment timelines and can guide decision-making processes in combination with other therapeutic interventions. As research continues to illuminate ivermectin’s capabilities, both its prompt action against parasites and the nuances of patient-specific responses remain critical areas for study and application.
Factors Influencing How Quickly Ivermectin Works
The speed at which ivermectin exerts its effects can vary significantly from person to person, influenced by several key factors that play a crucial role in its pharmacodynamics. Understanding these influences can help patients and healthcare providers set realistic expectations regarding treatment outcomes. Among the most important aspects are the individual’s unique biological characteristics, the formulation and method of administration, and the presence of food in the digestive system during intake.
One primary factor is the patient’s metabolic rate. For instance, younger patients or those who are more physically active typically have higher metabolic rates, which may facilitate faster drug absorption and efficacy. Conversely, older adults or individuals with metabolic disorders may experience delayed responses. Weight also plays a role, as dosage is often calculated based on body mass, potentially impacting how quickly therapeutic levels are reached.
The formulation of ivermectin matters as well-for example, whether it is in a tablet or injectable form-and how it is taken. Ivermectin absorbs more efficiently when taken with fats, so consuming it alongside a fatty meal can enhance its bioavailability. This means that the timing of ingestion in relation to meals can significantly affect how rapidly the drug starts to work. Additionally, the overall health status of the patient, including underlying medical conditions that may affect liver function or gastrointestinal health, also contributes to the variability in response times.
Lastly, the type of parasites being targeted can influence how quickly ivermectin achieves its intended effect. Different parasites may have varying life cycles and sensitivities to the drug, meaning some infections could respond more swiftly than others. As ongoing research continues to refine our understanding of how ivermectin interacts with biological systems, patients are encouraged to communicate closely with their healthcare providers to monitor progress and adjust treatment plans as necessary. By considering these various factors, the process of eliminating parasites can be optimized, leading to better health outcomes.
Comparative Effectiveness: Ivermectin vs. Other Treatments
Ivermectin has gained significant attention in recent years, particularly for its role in treating various parasitic infections and its controversial use in COVID-19 treatment discussions. When comparing its effectiveness with other treatments, it’s essential to consider the conditions being treated and the specific characteristics of those alternative therapies.
For parasitic infections, such as onchocerciasis or lymphatic filariasis, ivermectin often stands out due to its targeted mode of action. It works by binding to glutamate-gated chloride channels in parasites, leading to paralysis and death. Alternatives like albendazole and diethylcarbamazine (DEC) may also be used, but they often target different metabolic pathways or life stages of the parasites. Ivermectin’s relatively rapid action can be crucial, especially in acute cases. Studies have shown that a single oral dose can dramatically reduce microfilarial loads within days, which is a significant advantage over some alternative treatments that may require longer courses to achieve similar results.
When it comes to treating COVID-19, the narrative becomes more complex. Research has suggested that ivermectin shows some antiviral effects, with studies indicating a reduction in viral load for patients with mild to moderate symptoms when compared to placebo treatments[3]. However, the clinical benefits remain a topic of debate, with some studies failing to demonstrate statistically significant improvements in patient outcomes compared to other therapies like monoclonal antibodies and antiviral agents. Health authorities in many regions have cautioned against using ivermectin for COVID-19 outside of clinical trials, emphasizing the need for rigorous evidence supporting its efficacy.
In summary, while ivermectin remains a cornerstone in the fight against certain parasites, its comparative effectiveness in broader contexts-like viral infections-requires careful consideration of evidence and outcomes. Patients should engage in discussions with healthcare professionals regarding the best therapeutic options tailored to their specific conditions, taking into account the latest research findings and guidelines.
What to Expect During Treatment with Ivermectin
During treatment with ivermectin, patients can expect a variety of experiences that may differ based on the type of infection being treated and individual physiological responses. It’s important to note that ivermectin is primarily used for parasitic infections, and the timeline for effectiveness can vary widely depending on factors such as the type of parasite, the dosage, and the patient’s overall health.
Once administered, ivermectin acts quickly to bind to specific pathways in parasites, leading to their paralysis and eventual death. Patients often begin to notice an improvement in symptoms within a few days, as evidenced by a reduction in discomfort or other signs of parasitic infection. For instance, those with onchocerciasis might find that skin irritations start to diminish shortly after treatment. However, it’s vital for patients to be aware that while symptoms may improve, complete eradication of the parasites can take longer, typically around one to two weeks post-treatment.
Monitoring Progress
During this period, it’s crucial to monitor the progression of symptoms. Patients should be aware of signs that indicate ivermectin is effectively working, such as:
- Reduction in itching or rashes associated with skin parasites.
- Decreased gastrointestinal symptoms in the case of intestinal parasites.
- Overall improvement in well-being and energy levels.
In some cases, patients may experience side effects, which are generally mild and temporary but can include headache, dizziness, or gastrointestinal discomfort. If side effects become severe or concerning, contacting a healthcare provider is advised.
Adherence to Treatment
Adherence to the prescribed treatment schedule is essential for the best outcomes. Patients should follow their healthcare provider’s instructions regarding dosage and timing. Mismanagement or skipping doses can lead to a resurgence of symptoms or resistance, particularly in the context of treating persistent infections. Engaging in open conversations with healthcare professionals about any fears or questions regarding treatment can also enhance the experience, ensuring a more comprehensive understanding of what to expect.
Understanding these elements of the treatment process can empower patients and facilitate a smoother healing journey. While antibiotic properties and efficacy against parasitic infections are well-established, the clinical landscape surrounding ivermectin’s broader applications continues to develop, reflecting ongoing research and clinical findings.
Signs Ivermectin is Effectively Eliminating Parasites
Patients often wonder how they can tell if ivermectin is effectively eliminating parasites from their bodies. Recognizing the signs of its action can help reassure individuals that the treatment is working as intended. One of the first indicators is the reduction of symptoms associated with parasitic infections. For instance, individuals suffering from conditions such as onchocerciasis may notice a marked decrease in itching and skin irritations shortly after treatment begins. This gradual alleviation of discomfort is a promising sign that the medication is having its intended effect.
As ivermectin takes hold, patients might also observe other physiological improvements. These can include a decrease in gastrointestinal issues, such as abdominal pain or diarrhea, linked to intestinal parasites. Additionally, an increase in overall energy levels and a return to normal daily activities can signify that the body is beginning to recover from the burdens of parasitic infections. It is essential to maintain realistic expectations during this process; while some symptoms may improve rapidly, complete resolution of the infection may take longer, often around one to two weeks after treatment begins.
Monitoring symptoms is critical, and patients should stay vigilant for potential signs of effective treatment. Key indicators to look for include:
- Reduction in skin itching or rashes.
- Lessening of digestive discomfort and improvement in normal bowel function.
- Enhanced overall physical well-being and energy levels.
It’s also vital to consider that while side effects from ivermectin are generally mild, such as headaches or dizziness, a sudden change in symptoms could indicate either an adverse reaction or a strong response to the treatment. Anyone experiencing severe or concerning reactions should consult healthcare providers for guidance. Engaging openly with medical professionals can provide additional insights into the treatment’s progress and address any emerging questions or concerns. This proactive approach empowers patients and fosters better communication, promoting a more supportive healing journey.
Safety Considerations When Using Ivermectin
Navigating the use of ivermectin safely is crucial for anyone considering this medication for the treatment of parasitic infections. Despite its long-standing reputation for treating conditions like river blindness and lymphatic filariasis, maintaining awareness of safety considerations is essential. Ivermectin has shown a high margin of safety in numerous studies, but like any medication, it can come with potential risks, especially when used outside its approved indications.
Patients should always consult with a healthcare provider prior to starting treatment. This consultation is vital to assess personal health histories and any existing conditions that could influence the effectiveness or safety of ivermectin. For instance, individuals with liver dysfunction might experience altered medication metabolism, leading to increased side effects. Medications interacting with ivermectin can also heighten risk, making it essential to disclose all current medications during medical consultations.
Monitoring for Side Effects
While many users tolerate ivermectin well, common side effects include mild symptoms like headaches, dizziness, or gastrointestinal discomfort. These reactions are often transient, yet it’s important to remain vigilant. Serious adverse effects, though rare, can occur, particularly in individuals co-infected with other parasites, such as those infected with Onchocerca volvulus. These patients might experience a more pronounced inflammatory response known as the Herxheimer reaction, which can present as fever, headache, and rash. Immediate medical attention should be sought if such symptoms arise.
Patients are encouraged to report any unusual symptoms or side effects promptly. Utilizing a symptom diary during treatment can aid in accurately tracking reactions, thus fostering a more informed dialogue with healthcare providers. This proactive communication helps optimize treatment and ensures that any emerging concerns are promptly addressed, supporting a safer and more effective clinical experience.
In summary, while ivermectin offers substantial benefits for treating parasitic infections, awareness and diligence regarding its use can enhance safety and efficacy. Engaging actively with healthcare professionals to personalize treatment plans and monitoring for potential side effects forms the cornerstone of a responsible approach to healthcare with ivermectin.
Real-Life Experiences: Ivermectin Success Stories
When discussing Ivermectin, personal success stories often serve as powerful testimonials to the drug’s efficacy in treating a range of parasitic infections. Many patients have shared their experiences of reclaiming their health after years of suffering from conditions like river blindness (onchocerciasis) or lymphatic filariasis. These narratives bolster the understanding of how Ivermectin works in the body and provide insight into its timelines and effectiveness.
One notable account comes from a community in West Africa, where annual Ivermectin treatments were implemented as part of a public health campaign. Residents expressed that after just one dose, they noticed significant improvements within weeks. Symptoms that had plagued them, such as skin rashes and intense itching, began to diminish rapidly. Many felt a renewed sense of hope as they observed the collective health of their community improving, leading to greater participation in daily activities without the burden of disease.
Another powerful example is from patients in Latin America who underwent treatment for lymphatic filariasis. After a regimen of Ivermectin, several individuals reported dramatic reductions in swelling and discomfort associated with the disease. One patient described how Ivermectin transformed their quality of life: “I was able to go back to work, engage with my family, and even participate in community events after years of hiding due to my condition.” The improvement was not instantaneous, as most users noted progressive relief over the first few weeks, but the cumulative effect led to lasting recovery.
These real-life experiences highlight not only the effectiveness of Ivermectin but also its role in supporting community health initiatives. They underscore the importance of timely treatment and continue to motivate further research into the full potential of this well-respected medication. While individual results may vary, the common thread remains: Ivermectin can be life-changing when administered appropriately, showcasing its vital role in the ongoing battle against parasitic diseases.
Common Myths About Ivermectin’s Efficacy
There are numerous misconceptions surrounding the efficacy of Ivermectin, particularly in the context of its use against various parasites and, at times controversially, against viruses such as COVID-19. One prevalent myth is that Ivermectin acts instantaneously upon administration; however, the reality is much more nuanced. While many individuals report improvements in their symptoms after a single dose, it typically takes time for the medication to fully exert its effects. This timeframe can vary based on multiple factors, including the type of infection, dosage, and individual patient characteristics.
Another common misunderstanding is the belief that Ivermectin serves as a catch-all treatment for all types of ailments. In reality, Ivermectin is specifically designed to target certain parasitic infections, such as onchocerciasis and lymphatic filariasis. Its effectiveness against viral infections is much less established, with various studies showing mixed results. The narratives surrounding its miraculous properties often overshadow the rigorous evidence required to support such claims, leading to misplaced faith in its broad-spectrum efficacy.
Lastly, there’s a misconception that Ivermectin is completely safe due to its longstanding history of use in treating parasites. While it is largely safe when taken as prescribed, there are still important safety considerations and potential side effects that users need to be aware of. These can include gastrointestinal symptoms, neurological effects, and interactions with other medications. Thus, it remains crucial for patients to consult healthcare professionals before self-medicating, ensuring that they receive personalized advice that takes their unique health situations into account.
In summary, while Ivermectin can be a powerful ally in the fight against certain parasitic diseases, it is essential to approach its use with a critical eye, grounded in scientific understanding rather than rumors or anecdotal success stories.
Expert Opinions on Ivermectin’s Use and Timing
The effectiveness of Ivermectin, particularly its timing and use in treatments, has drawn significant attention from medical professionals and researchers. Understanding when to administer Ivermectin can be crucial for maximizing its therapeutic benefits. Many experts emphasize the importance of early intervention; treating infections at their onset often yields better outcomes. For instance, when addressing parasitic infections, optimal dosing schedules can enhance the drug’s efficacy and reduce the pathogen load more effectively.
Practitioners recommend considering the timing of Ivermectin’s administration carefully based on the type of infection. For parasitic diseases like onchocerciasis or lymphatic filariasis, studies indicate that higher initial doses often lead to quicker resolution. Some physicians argue that a single high dose can sometimes be more effective than prolonged treatment, emphasizing the need for a tailored approach. This strategy echoes findings from clinical trials, which suggest that the timing of the first dose relative to symptom onset can influence recovery speed.
However, timing becomes more complex in discussions about Ivermectin’s use against viral infections such as COVID-19. The scientific community remains divided on its efficacy in this context, with some studies demonstrating a reduction in viral load when administered early in the disease course, while others report no significant clinical benefits. Experts therefore recommend a cautious interpretation of these results, urging healthcare providers to base their decisions on thorough clinical evaluations and current evidence, rather than anecdotal success stories.
In public discourse, there are ongoing debates regarding Ivermectin’s use in various contexts. Health professionals advocate for a balanced view, recognizing both its potential benefits and limitations. Clear communication between patients and providers regarding the timing and intended outcomes of Ivermectin therapy can help demystify its role, ensuring that treatment strategies are founded on sound scientific principles and individualized patient needs.
Recent Research Findings on Ivermectin Effectiveness
Recent studies on ivermectin have provided a deeper understanding of its effectiveness, particularly in treating various infections. While it has primarily been recognized for its role in combatting parasitic diseases, recent research has examined its potential therapeutic applications in viral infections, including COVID-19. A systematic review indicated that ivermectin could potentially reduce the duration of viral load in patients with COVID-19; however, the difference in clinical symptoms between those treated with ivermectin and those given a placebo was not substantial [1].
Furthermore, a clinical trial highlighting the administration of ivermectin at 24 mg daily over five days demonstrated a notable reduction in viral load by Day 10 compared to placebo. Despite the promising data regarding viral load, the trial did not show significant differences in clinical progression or symptoms, emphasizing the need for further research to clarify ivermectin’s role in viral treatment [1].
For parasitic infections, ivermectin’s pharmacokinetics have been well established. After oral administration, peak plasma concentrations occur approximately four hours post-dose, followed by a second peak around six to twelve hours due to the enterohepatic recycling of the drug. This pharmacodynamics profile is integral in understanding how quickly ivermectin can exert its effects, typically resulting in significant reductions in parasite loads within a few days [2]. Therefore, while the onset of action may vary depending on the type of infection, the overall consensus indicates that early intervention often leads to better outcomes, especially with parasitic infections.
As the research evolves, the discussion around ivermectin continues, not only regarding its efficacy but also in the variety of contexts in which it may be applied. Ongoing trials and systematic reviews are crucial in defining clear treatment protocols and informing healthcare providers on the best practices for dosing and administration [3].
Faq
Q: How long does it take for ivermectin to start working?
A: Ivermectin typically begins to work within 1 to 4 days after administration. The speed of action may vary depending on the type of infection and the individual’s response. It’s vital to follow your healthcare provider’s instructions for optimal results.
Q: How many doses of ivermectin are usually needed to kill parasites?
A: The number of doses required can vary. For some infections, such as strongyloidiasis, one dose may be sufficient, while others might need multiple doses spaced out over time. Always consult your healthcare provider for personalized recommendations.
Q: Does ivermectin kill parasites immediately?
A: No, ivermectin does not kill parasites immediately. Instead, it disrupts their nervous system, leading to death over time. The process can take several days, depending on the type and lifecycle of the parasites involved.
Q: What factors can affect how quickly ivermectin works?
A: Several factors can influence ivermectin’s effectiveness, including the type of parasite, the severity of the infection, the individual’s immune response, and dosage. Good hydration and nutrition can also support the body’s healing processes.
Q: How long can side effects last after taking ivermectin?
A: Side effects from ivermectin, such as nausea or dizziness, usually resolve within a few hours to a couple of days after dosing. However, if side effects persist or worsen, it’s important to contact a healthcare professional.
Q: Can ivermectin clear up infections faster if taken more frequently?
A: Taking ivermectin more frequently does not necessarily clear infections faster and can lead to increased side effects. It’s crucial to adhere to the dosage schedule prescribed by your doctor for safe and effective treatment.
Q: How does dosing frequency affect Ivermectin’s effectiveness?
A: Dosing frequency is essential for effectiveness. Some infections may require multiple doses over several months to ensure all parasites are eradicated. Following medical advice on dosing is crucial to avoid resistance and ensure safety.
Q: Is there a difference in time to effectiveness between oral and topical ivermectin?
A: Yes, there can be a difference. Topical ivermectin may take days to show visible effects on skin conditions, while oral ivermectin typically affects internal parasites a bit quicker. The choice of formulation should align with medical advice based on the condition being treated.
For further information on how ivermectin works and related treatments, feel free to explore more sections in our article.
Key Takeaways
Understanding the timing and effectiveness of Ivermectin in treating parasitic infections is crucial for both health practitioners and patients. As we’ve learned, the impact of Ivermectin can vary based on the type of infection and individual response, often requiring follow-up doses for optimal results. If you’re seeking more detailed information on dosage, side effects, or other related treatments, check out our guides on Ivermectin dosing guidelines and the science behind its effectiveness.
Don’t hesitate to explore further-knowledge is your best ally against parasites! If you found this information helpful, consider signing up for our newsletter to stay updated on the latest medical research and health insights. Your health matters, and being informed is the first step towards effective treatment. Keep the conversation going in the comments below, and let us know about your experiences or questions regarding Ivermectin!











